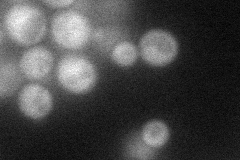
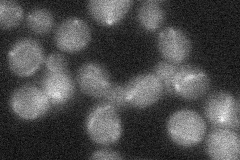

View description
Dual-specificity protein phosphatase; exists in 2 isoforms; required for maintenance of a low level of signaling through the cell integrity pathway, adaptive response to pheromone; regulates and is regulated by Slt2p; dephosphorylates Fus3p
Localization:
Intensity:
Fold change:
Significance:
-
C’ GFP library in SD

cytosol23.51 -
N' NOP1pr-GFP in SD
cytosol44.2435 -
N' TEF2pr-mCherry in SD

cytosol40.5654 -
N' NATIVEpr-GFP in SD
below threshold21.5987 -
N' TEF2pr-VC and Cyto-VN in SD

#N/A0 -
C’ GFP library in SD+DTT

cytosol22.720.96No -
C’ GFP library in SD+H2O2

cytosol25.011.06No -
C’ GFP library in Starvation Media

punctateN/AN/AYes -
C’ GFP library on the background of Pup2-DaMP

cytosol -
C’ GFP library on the background of CCT mutant

cytosol28.86171.22739No
